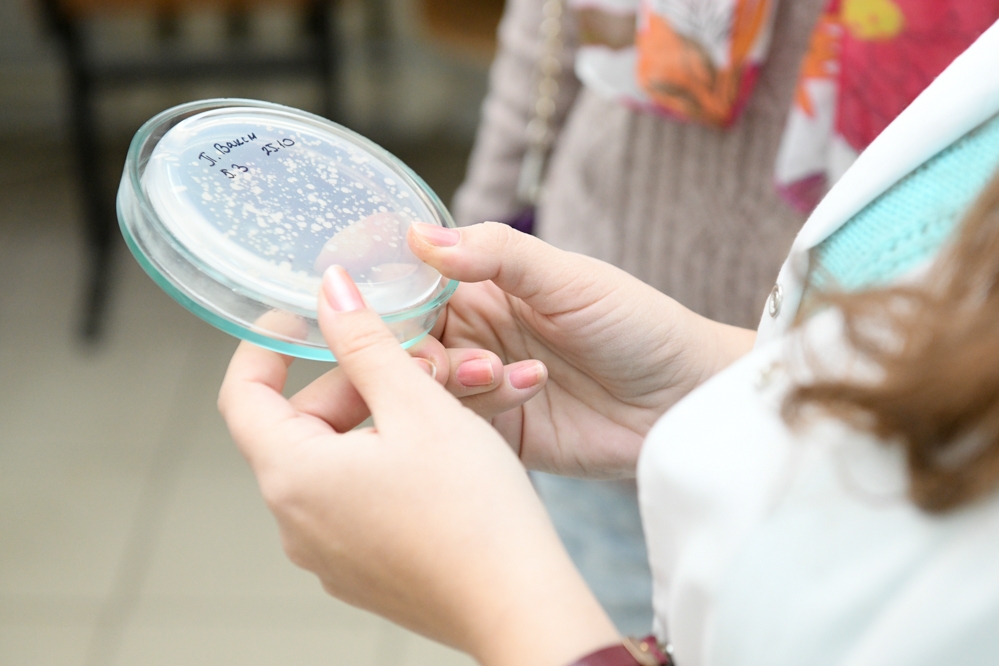
#abitur_tour: даже на расстоянии!

- 29.10.2018
- Дмитрий Литвинов
#abitur_tour: даже на расстоянии!
У школьников начались осенние каникулы, а в Тульском государственном университете продолжается #abitur_tour — нескучное знакомство с опорным вузом и работодателями.
Утро понедельника началось с экскурсии в лаборатории Естественнонаучного института ТулГУ. Аналитическая, органическая и неорганическая, биохимия… Спектр научных знаний студентов, а, значит, и приложения профессиональных сил выпускников — широкий.
— Наши выпускники работают на предприятиях пищевой промышленности, непосредственно на химическом производстве, ведь химия в Тульской области — одна из ведущих отраслей, и даже в музеях и в полиции. Да-да, в музее «Куликово поле» трудятся биологи, а химики — в экспретно-криминалистическом отделе МВД, — рассказывала аспирант кафедры химии Дарья Лаврова. — Кроме того, у наших биотехнологов в учебном плане немало технических дисциплин, поэтому они могут работать на реальном производстве. Есть и те, кто идёт в науку — занимаются исследованиями и разработками в стенах нашего вуза и не только…
В химических лабораториях ассистент кафедры Наталья Юдина демонстрировала сложные приборы, работу которых изучают студенты — биосенсорные установки различного типа, в том числе портативные, позволяющие работать не только в лабораторных условиях, но и на различных объектах.
Заведующая учебными лабораториями Елена Ягольник продемонстрировала работу оборудования для культивирования клеток в стерильных условиях. Микробиология — одна из сфер, в которой могут работать выпускники Естественнонаучного института ТулГУ.
С интересом наблюдала за происходящим тулячка Марина Максимова, пришедшая на #abitur_tour по просьбе своих племянников, один из которых учится в 7-м, а другой в 4-м классе.
— Ребята живут в Рязани, но интересуются Тулой и нашим университетом, — рассказала Мария. — Они попросили меня побольше узнать о ТулГУ, поэтому я постаралась записаться на все экскурсии. Причём мы не просто увидели работу оборудования, а смогли понаблюдать за учебным процессом, ведь в это время шли обычные пары у студентов. Я увидела, как студенты-химики строят на компьютерах чертежи химических молекул, в лабораториях в центрифугах отделяют культуры бактерий от сред, и взращивают другие бактерии в чашках Петри. Узнала, что студенты-биологи каждое лето выезжают на полевую практику — это очень интересно!..